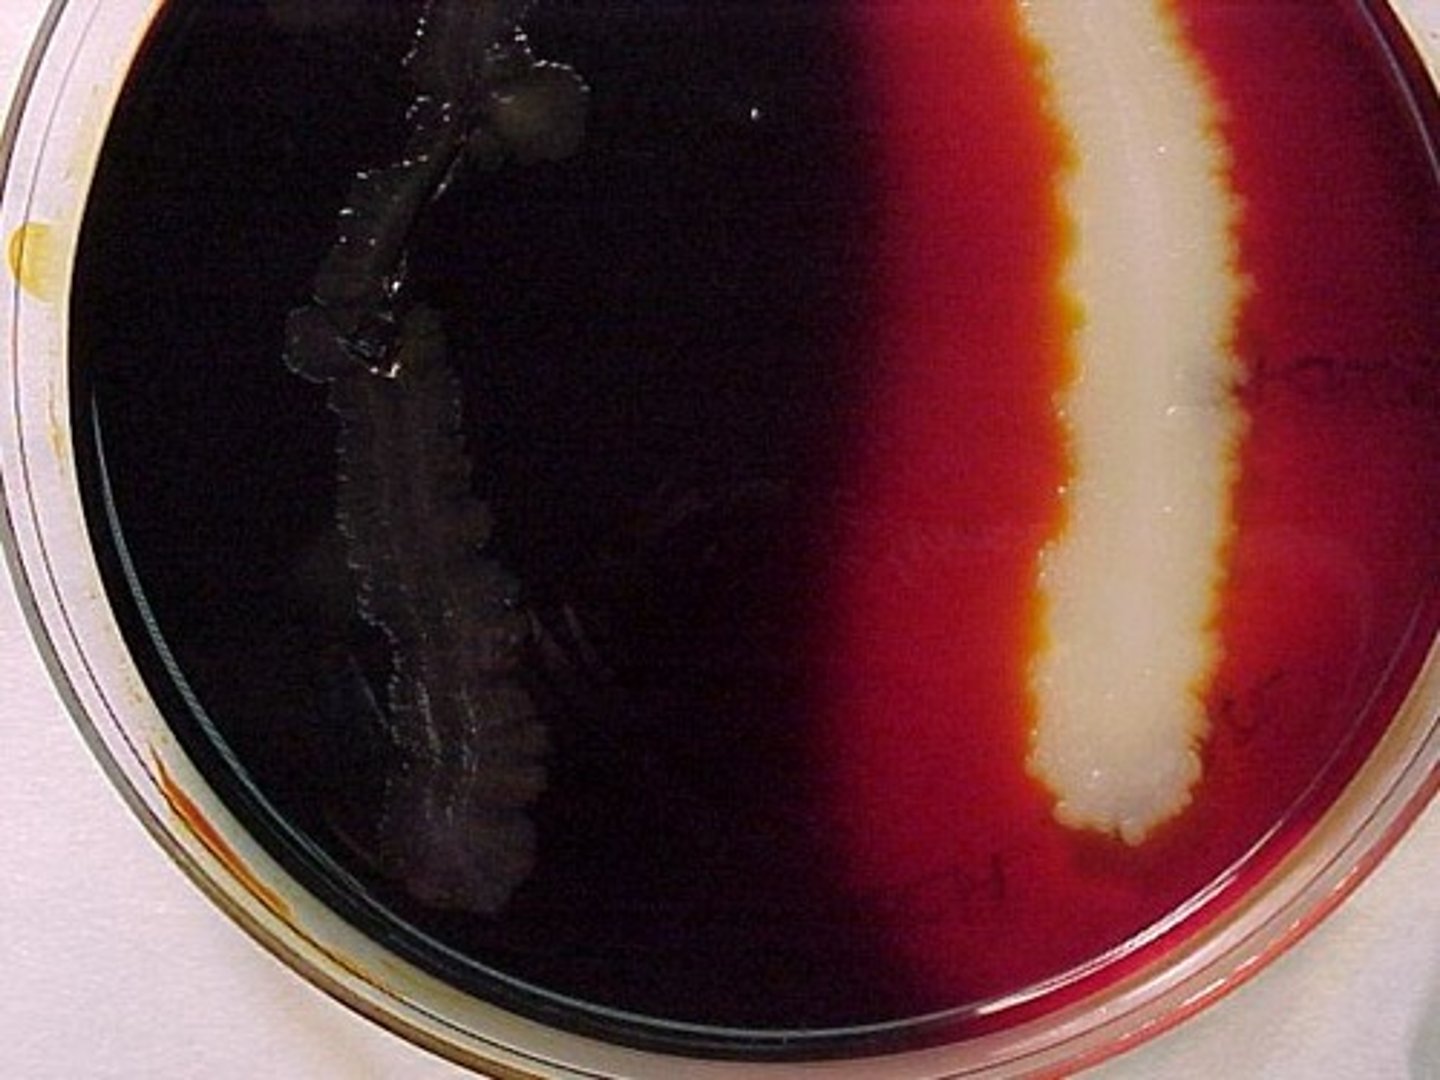
<p>STARCH HYDROLYSIS (AMYLASE TEST)</p><p>NO clearing around growth indicates . . .</p>

BY 206 Lab Tope Week 7 (Ex 2-7; 5-4, 7, 9, 10, 13, 16, 30)
1/76
There's no tags or description
Looks like no tags are added yet.
Name | Mastery | Learn | Test | Matching | Spaced | Call with Kai |
|---|
No analytics yet
Send a link to your students to track their progress
77 Terms
. . . . .
FLUID THIOGLYCOLLATE BROTH
anaerobic, microaerophilic
FLUID THIOGLYCOLLATE BROTH
This liquid medium promotes the growth of a variety of fastidious to nonfastidious microorganisms. It is generally associated with the cultivation of ____ and ____ bacteria.
yeast extract and pancreatic digest of casein
FLUID THIOGLYCOLLATE BROTH
Key components of this medium are yeast extract, pancreatic digest of casein, dextrose, sodium thioglycollate, L-cysteine, and resazurin.
Which two provide nutrients to the medium?
sodium thioglycollate and L-cysteine
FLUID THIOGLYCOLLATE BROTH
Key components of this medium are yeast extract, pancreatic digest of casein, dextrose, sodium thioglycollate, L-cysteine, and resazurin.
Which two reduce oxygen to water?
resazurin
*pink when oxidized, colorless when reduced
FLUID THIOGLYCOLLATE BROTH
Key components of this medium are yeast extract, pancreatic digest of casein, dextrose, sodium thioglycollate, L-cysteine, and resazurin.
Which one acts as an indicator of O₂?

aerotolerant anaerobe
*doesn't need oxygen for growth but can tolerate its presence; growth all throughout the medium
FLUID THIOGLYCOLLATE BROTH
What type of organism is this based on their aerotolerance?

facultative anaerobe
*doesn't need oxygen for metabolism but uses it when it's present; growth all throughout but heavier at the top
FLUID THIOGLYCOLLATE BROTH
What type of organism is this based on their aerotolerance?

strict anaerobe
*lack the metabolic enzyme system for using oxygen, so it's poisoned by it; growth is heavier at the bottom
FLUID THIOGLYCOLLATE BROTH
What type of organism is this based on their aerotolerance?

strict aerobe
*need oxygen to grow; heavy growth at the top where oxygen is most plentiful
FLUID THIOGLYCOLLATE BROTH
What type of organism is this based on their aerotolerance?

microaerophile
*requires only small amounts of oxygen; grows near the top
FLUID THIOGLYCOLLATE BROTH
What type of organism is this based on their aerotolerance?

. . . . .
METHYL RED & VOGES-PROSKAUER TESTS (MR-VP)
IMViC (Indole, Methyl red, Voges-Proskauer, Citrate)
MR-VP TESTS
The methyl red and Voges-Proskauer tests are components of what battery of tests?
Enterobacteriaceae
MR-VP TESTS
The methyl red and Voges-Proskauer tests are used to distinguish between members of the family ____ and differentiate them from the other G(-) rods.
peptone
MR-VP TESTS
Methyl red and Voges-Proskauer broth contains peptone, glucose, and a phosphate buffer.
Which is used to provide protein?
glucose
MR-VP TESTS
Methyl red and Voges-Proskauer broth contains peptone, glucose, and a phosphate buffer.
Which is used to provide fermentable carbohydrate?
phosphate buffer (potassium phosphate)
MR-VP TESTS
Methyl red and Voges-Proskauer broth contains peptone, glucose, and a phosphate buffer (potassium phosphate).
Which is used to resist pH changes in the medium?
mixed acid fermentation
*overcomes the phosphate buffer and lowers the pH (produces stable acid end products)
MR-VP TESTS (methyl red test)
The Methyl red test detects organisms capable of performing . . .

MR-VP TESTS (methyl red test)
MR (+) organisms lower the broth's pH permanently.
methyl red indicator dye
MR-VP TESTS (methyl red test)
Following incubation, mixed acid fermentation is verified by the addition of what?
-positive test
-mixed acid fermentation
MR-VP TESTS (methyl red test)
A red color indicates . . .

4.4
MR-VP TESTS (methyl red test)
Methyl red is red at pH ___.
-negative test
-no mixed acid fermentation
MR-VP TESTS (methyl red test)
A yellow color indicates . . .

6.2
MR-VP TESTS (methyl red test)
Methyl red is yellow at pH ___.
a negative or inconclusive test
MR-VP TESTS (methyl red test)
An orange color indicates . . .
organisms that are capable to ferment glucose, but quickly convert their acid products to acetoin and 2,3-butanediol
MR-VP TESTS (VP test)
The Voges-Proskauer (VP) test was designed for . . .
MR-VP TESTS (VP test)
VP(+) organisms initially may produce acid and temporarily lower the pH, but because the 2,3-butanediol fermentation end products are neutral, the pH at completion of the test is near neutral.

diacetyl
MR-VP TESTS (VP test)
Adding VP reagents oxidizes acetoin to . . .
guanidine nuclei
MR-VP TESTS (VP test)
Diacetyl reacts with ____ from peptone to produce a red color.
-positive test
-2,3 butanediol fermentation (acetoin produced)
MR-VP TESTS (VP test)
A red color indicates . . .

-negative test
-NO 2,3 butanediol fermentation (acetoin is not produced)
MR-VP TESTS (VP test)
No color change (or development of copper color) indicates . . .


. . . . .
OXIDASE TEST
cytochrome c oxidase
OXIDASE TEST
The oxidase test is designed to identify bacteria containing the respiratory enzyme . . .
Neisseria, Moraxella
OXIDASE TEST
It is used for the presumptive identification of the oxidase (+) ____ and ____.
Enterobacteriaceae, Pseudomonadaceae
OXIDASE TEST
It is also used to differentiate the oxidase (-) ____ from the oxidase (+) ____.
tetramethyl-p-phenylenediamine
OXIDASE TEST
Cytochrome c oxidase oxidizes and catalyzes the reduction of cytochrome c by a chromogenic reducing agent called . . .
flavoproteins, iron-sulfur proteins, and cytochromes
OXIDASE TEST
What are three important ETC molecules unable to donate protons?
20 seconds
OXIDASE TEST
How much time is allotted for a color change to occur after adding the reagent?
-positive test
-cytochrome c oxidase is present
OXIDASE TEST
Dark blue/purple within 20 seconds indicates . . .

-negative test
-cytochrome c oxidase NOT present
OXIDASE TEST
NO color change to dark blue/purple within 20 seconds indicates . . .

. . . . .
CITRATE UTILIZATION TEST
Enterobacteriaceae
CITRATE UTILIZATION TEST
This test was designed to differentiate members of the ____, all of which are facultative anaerobes.
IMViC (Indole, Methyl red, Voges-Proskauer, Citrate)
CITRATE UTILIZATION TEST
This test is part of a test series known as the . . .
sodium citrate
CITRATE UTILIZATION TEST
The citrate utilization test is used to determine the ability to use ____ as its sole source of carbon.
Simmons citrate agar
*defined medium
CITRATE UTILIZATION TEST
What agar is used?
citrate permease
CITRATE UTILIZATION TEST
What enzyme do bacteria possess to transport citrate into the cell and perform citrate fermentation?
ammonium (in the form of ammonium phosphate)
CITRATE UTILIZATION TEST
These organisms must also be able to survive with ____ as their sole nitrogen source.
citrate lyase
CITRATE UTILIZATION TEST
What enzyme hydrolyzes citrate into oxaloacetate and acetate?
bromothymol blue dye
*green at pH 6.9
*blue at pH 7.6
CITRATE UTILIZATION TEST
What is used as a color indicator?
-positive test
-citrate is utilized
CITRATE UTILIZATION TEST
A blue color indicates . . .

-positive test
-citrate is utilized
CITRATE UTILIZATION TEST
No color change, but growth on the slant indicates . . .

-negative test
-citrate is NOT utilized
CITRATE UTILIZATION TEST
No color change, and no growth on the slant indicates . . .

. . . . .
MALONATE UTILIZATION TEST
Enterobacteriaceae
MALONATE UTILIZATION TEST
The malonate test differentiate between Escherichia and Enterobacter, but now includes ____.
succinate dehydrogenase
MALONATE UTILIZATION TEST
What enzyme does the citric acid cycle require to convert succinate into fumarate?
malonate (malonic acid)
MALONATE UTILIZATION TEST
What is added to the medium to replace succinate as the substrate in the reaction?
glucose
MALONATE UTILIZATION TEST
What is added to the medium to promote growth of organisms that are slow to respond?
buffers
MALONATE UTILIZATION TEST
What is added to the medium to stabilize it at pH 6.7?
-positive test
-malonate is utilized
MALONATE UTILIZATION TEST
A dark blue color indicates . . .

-negative test
-malonate is NOT utilized
MALONATE UTILIZATION TEST
NO color change or a slightly yellow color indicates . . .

. . . . .
STARCH HYDROLYSIS (AMYLASE TEST)
Gardnerella vaginalis
STARCH HYDROLYSIS (AMYLASE TEST)
Starch agar was originally designed for cultivating Neisseria. But it is now used to isolate and presumptively identify . . .
STARCH HYDROLYSIS (AMYLASE TEST)
Starch agar also aids in differentiating members of the genera Corynebacterium, Clostridium, Bacillus, Bacteroides, Fusobacterium, and Enterococcus.
α-amylase and oligo-1,6-glucosidase
STARCH HYDROLYSIS (AMYLASE TEST)
Organisms that produce and secrete the extracellular enzymes ____ and ____ are able to hydrolyze starch.
iodine
STARCH HYDROLYSIS (AMYLASE TEST)
What reagent is added to detect the presence or absence of starch in the vicinity around the bacterial growth?
-positive test
-α-amylase/oligo-1,6-glucosidase are present
STARCH HYDROLYSIS (AMYLASE TEST)
Clearing around growth indicates . . .

-negative test
-α-amylase/oligo-1,6-glucosidase is NOT present
STARCH HYDROLYSIS (AMYLASE TEST)
NO clearing around growth indicates . . .
. . . . .
CASEIN HYDROLYSIS (CASEASE TEST)
casease
CASEIN HYDROLYSIS (CASEASE TEST)
The casein hydrolysis test is used for the cultivation and differentiation of bacteria that produce the enzyme ____.
casein
*what gives milk its white color
CASEIN HYDROLYSIS (CASEASE TEST)
Casease hydrolyzes the milk protein . . .
undefined
CASEIN HYDROLYSIS (CASEASE TEST)
What type of medium is milk agar?
-positive test
-casease is present
CASEIN HYDROLYSIS (CASEASE TEST)
Clearing in agar indicates . . .

-negative test
-casease is absent
CASEIN HYDROLYSIS (CASEASE TEST)
NO clearing in agar indicates . . .

ur doing great hun

. . . . .
ENTEROPLURI-TEST (ENTEROTUBE II)
Enterobacteriaceae
ENTEROTUBE II
The Enterotube II is a multiple test system used for rapid identification of bacteria from the family ____.
enteric
ENTEROTUBE II
The Enterotube II is used to identify ____ bacteria based on glucose, adonitol, lactose, arabinose, sorbitol, dulticotl fermentation, lysine and ornithine decarboxylation, sulfur reduction, indole production, acetoin production from glucose fermentation, phenylalanine deamination, urea hydrolysis, and citrate utilization.